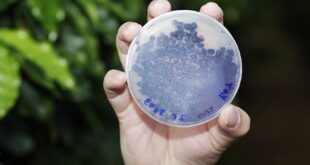

Projeto de lei segue, agora, para análise da Comissão de Esporte em 2º turno. Projeto sobre e-sports, de autoria do Deputado Coronel Henrique, foi aprovado em 1º turno na tarde desta quarta (6) / Foto: Daniel Protzner Diretrizes para a prática de jogos eletrônicos no Estado, os chamados e-sports, foram aprovadas em Reunião de …
Leia Mais »Leis publicadas estão voltadas a diabéticos e a pessoas com marca-passo
Os dois textos tiveram origem de projetos aprovados pela Assembleia. Legislação prevê estímulo à realização de campanhas de conscientização sobre o diabetes – Arquivo ALMG / Foto: Ricardo Barbosa Duas leis publicadas no Diário Oficial desta quinta-feira (23/4/26) podem beneficiar pessoas com problemas de saúde. A Lei 25.830, de 2026, altera a Lei 14.533, …
Leia Mais »Reunião da Assembleia debate o trabalho escravo em Minas
Nos últimos dois anos, Ministério do Trabalho resgatou 1.067 trabalhadores em condições degradantes em Minas. Lista Suja do Trabalho Escravo em Minas Gerais foi entregue na Assembleia no dia 15 de abril – Arquivo ALMG / Foto: Willian Dias Nesta sexta-feira (24/4/26), a partir das 14 horas, a Assembleia Legislativa …
Leia Mais »Produtores de cachaça premiados recebem congratulações na ALMG
Serão homenageados fabricantes de cachaça artesanal vencedores do concurso promovido pela Emater, em novembro do ano passado. A cachaça mineira tem conquistado cada vez mais mercado e premiações – Arquivo ALMG / Foto: Luiz Santana Nesta quinta-feira (9/4/26), vencedores do 2º Concurso de Avaliação da Qualidade das Cachaças de Alambique e Aguardentes de Cana Mineiras, promovido pela …
Leia Mais »Operação Última Ordem: PCMG e PCERJ prendem liderança de grupo criminoso
Divulgação/PCMG A Polícia Civil de Minas Gerais (PCMG), em ação integrada com a Polícia Civil do Estado do Rio de Janeiro (PCERJ) e com o apoio da Polícia Militar (PMMG), deflagrou, nesta terça-feira (7/4), a operação Última Ordem. O objetivo foi desarticular a cúpula de uma organização criminosa de abrangência …
Leia Mais »Tradição em Minas, rodeios terão aprimoramento debatido em audiência
Objetivo é conciliar importância cultural e econômica da atividade com protocolos para proteção de animais, peões e público. Antonio Carlos Arantes ressalta que Minas tem tradição na realização de rodeios, que movimentam expressivos recursos financeiros e geram empregos – Arquivo ALMG / Foto: Luiz Santana Os impactos econômicos e a sustentabilidade dos rodeios no …
Leia Mais »Enfrentamento ao feminicídio é desafio para o governo e para a sociedade
Para participantes de audiência pública, é preciso fortalecer instituições que atuam em defesa das mulheres. As Comissões do Trabalho e de Defesa dos Direitos da Mulher debateram a importância das instituições de proteção das mulheres / Foto: Elizabete Guimarães O fortalecimento das instituições que atuam em defesa das mulheres foi defendido …
Leia Mais »Defesa Civil e Programa Encontro das Águas pautam audiência na ALMG
Atuação do órgão na coordenação de ações integradas em prol do semiárido mineiro será debatida e homenageada nesta quinta (26) com entrega de votos de congratulações. O Programa Encontro das Águas reúne investimentos superiores a R$ 600 milhões e mobiliza em uma só agenda diversos órgãos públicos e privados do …
Leia Mais »Dólar fecha em R$ 5,16 e atinge menor valor em 20 meses
Bolsa encosta nos 191 mil pontos, mas cai influenciada por exterior Em meio à cautela dos investidores com a política tarifária do presidente Donald Trump, o dólar voltou a cair e a fechar no menor valor em 20 meses. A bolsa de valores iniciou o dia em alta, mas reverteu …
Leia Mais »Busca de soluções para crise climática pauta ações da Assembleia Legislativa
Atividades integram Programa de Aceleração de novas tecnologias e Plano Legislativo de Articulação e Monitoramento. Bioinseticida microbiológico possibilita o controle de pragas de diferentes lavouras de modo mais sustentável – Arquivo ALMG / Foto: Guilherme Bergamini Neste ano, a busca de soluções para a crise climática motivou discussões públicas, proposições de lei e …
Leia Mais » Barão Urgente
Barão Urgente